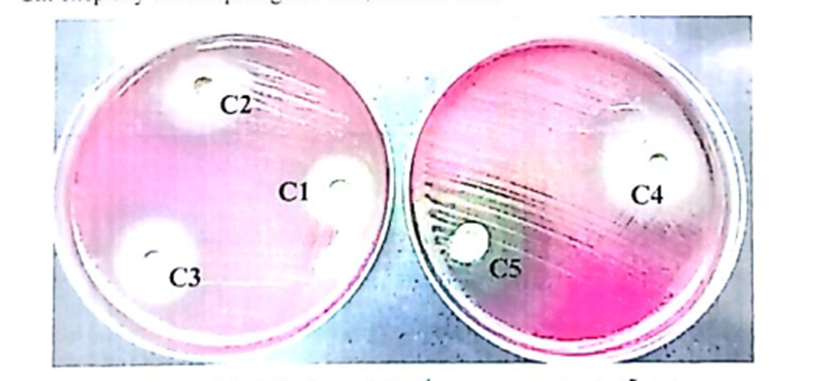

Đánh giá hiệu quả ức chế vi khuẩn HP của thực phẩm bảo vệ sức khỏe Bình Vị Thái Minh
Vi khuẩn HP là nguyên nhân hàng đầu gây viêm loét dạ dày. Nhằm chứng minh sản phẩm thực phẩm bảo vệ sức khỏe Bình Vị Thái Minh không chỉ hiệu quả đối với người bị trào ngược dạ dày mà còn với cả người viêm loét và đau dạ dày, Bình Vị Thái Minh tiến hành đánh giá hiệu quả ức chế vi khuẩn HP tại Bệnh viện Quân Y 103 và Học viện Quân Y với sự dẫn dắt của các giáo sư đầu ngành.
Tại sao cần ức chế vi khuẩn HP?
Vi khuẩn HP là nguyên nhân hàng đầu gây viêm loét dạ dày. Nếu không được điều trị kịp thời sẽ gây ra nhiều biến chứng như hẹp môn vị, thủng ổ loét, xuất huyết dạ dày… Vi khuẩn HP còn là “thủ phạm” gây ung thư dạ dày – căn bệnh nguy hiểm có nguy cơ tử vong rất cao.
![]() |
Để điều trị hiệu quả căn bệnh này, bên cạnh việc sử dụng kháng sinh còn kết hợp với thuốc giảm tiết acid. Tuy nhiên, hiện nay tỉ lệ kháng kháng sinh của HP rất cao nên việc điều trị gặp rất nhiều trở ngại. Các bác sĩ cảnh báo môi trường acid trong dạ dày có thể làm mất tác dụng của kháng sinh. Vi khuẩn HP lại nằm sâu dưới lớp chất nhầy và trong môi trường acid nên có thể dễ dàng “lẩn trốn” được kháng sinh điều trị bệnh.
Hơn nữa kháng sinh còn tiêu diệt cả vi khuẩn có lợi nên nhiều người bệnh khi dùng dài ngày thường gặp phải các tác dụng phụ như rối loạn tiêu hoá, cơ thể mệt mỏi..v..v cùng với nỗi sợ ảnh hưởng đến gan thận nên bỏ dở giữa chừng, không tuân thủ phác đồ điều trị.
![]() |
Vi khuẩn HP kháng thuốc là vấn đề đáng báo động hiện nay
Mặt khác, đặc thù của vi khuẩn HP là dễ lây lan, nên cho dù diệt trừ được vi khuẩn HP thì vẫn có khả năng tái nhiễm. Do đó, sau những đợt dùng kháng sinh theo phác đồ điều trị thì sử dụng các sản phẩm có nguồn gốc thảo dược an toàn, lành tính để ức chế vi khuẩn HP, giảm tiết acid, làm lành vết loét dạ dày là lựa chọn tối ưu. Khi dạ dày khỏe mạnh thì vi khuẩn HP sẽ không còn đáng ngại. Đây cũng là mục tiêu cao nhất của quá trình điều trị.
Giải pháp cho người bị viêm loét dạ dày, nhiễm khuẩn HP
Tháng 2/2022 Khoa Vi sinh, Bệnh viện Quân Y 103 và Học viện Quân y đã thực hiện nghiên cứu chứng minh hiệu quả ức chế vi khuẩn HP của thực phẩm bảo vệ sức khỏe Bình Vị Thái Minh.
Nghiên cứu được thực hiện theo quy trình gồm các bước:
- Vi khuẩn HP sau khi được khôi phục và tăng sinh từ các chủng bào sẽ pha thành các huyền dịch vi khuẩn
- Ria cấy huyền dịch vi khuẩn lên đĩa kháng sinh đồ. Đục lỗ trên bề mặt đĩa kháng sinh đồ, đánh dấu nồng độ ở từng lỗ
- Tra dung dịch thực phẩm bảo vệ sức khỏe Bình Vị Thái Minh đã được pha theo 5 nồng độ khác nhau từ C1 đến C5 (tương ứng 1 đến 5 viên) vào từng lỗ trên kháng sinh đồ
- Nuôi cấy trong môi trường Genbag Microaer (BioMeriux – Nhật), theo dõi sự phát triển của khuẩn lạc HP và đường kính vòng vô khuẩn
![]() |
Hình ảnh vòng vô khuẩn xung quanh các lỗ chứa dung dịch thực phẩm bảo vệ sức khỏe Bình Vị Thái Minh ở 5 nồng độ khác nhau
Tiêu chí đánh giá: Dựa vào đường kính vòng vô khuẩn theo từng nồng độ của Bình Vị Thái Minh. Đường kính vòng vô khuẩn càng lớn, khả năng ức chế vi khuẩn HP càng mạnh
Sau nghiên cứu, các bác sĩ tại khoa Vị sinh Bệnh viện Quân Y 103, Học viện Quân Y đưa ra kết luận: Bình Vị Thái Minh có tác dụng ức chế rõ ràng sự phát triển của vi khuẩn HP. Hiệu quả tăng dần tương ứng với sự tăng liều từ 1 đến 5 viên.
Như vậy với nghiên cứu này, người bị viêm loét, đau dạ dày nhiễm khuẩn HP có thể hoàn toàn yên tâm về hiệu quả của thực phẩm bảo vệ sức khỏe Bình Vị Thái Minh. Sản phẩm mang đến 4 cơ chế tác động trọn vẹn cho bệnh lí dạ dày:
- Ức chế vi khuẩn HP – Nguyên nhân hàng đầu gây viêm loét và đau dạ dày
- Bao bọc, bảo vệ niêm mạc dạ dày khỏi sự bào mòn của acid dịch vị, hồi phục vết loét
- Trung hòa, giảm tiết acid dịch vị ngăn hiện tượng trào ngược acid dạ dày
- Kích thích tiêu hóa, tăng tốc độ tháo rỗng của dạ dày, giảm trào ngược, đầy bụng, ợ hơi, ợ chua.
![]() |
Cũng theo kết quả khảo sát người tiêu dùng thuộc chương trình Tin dùng Việt Nam 2022 cho thấy:
- 98% người tiêu dùng hài lòng về hiệu quả của thực phẩm bảo vệ sức khỏe Bình Vị Thái Minh
- Thực phẩm bảo vệ sức khỏe Bình Vị Thái Minh là sản phẩm hàng đầu Việt Nam dành cho người bị trào ngược dạ dày, viêm loét và đau dạ dày
Thực phẩm bảo vệ sức khỏe Bình Vị Thái Minh đã có mặt tại 15.000 nhà thuốc trên toàn quốc.
Lưu ý, sản phẩm này không phải là thuốc và không có tác dụng thay thế thuốc chữa bệnh.